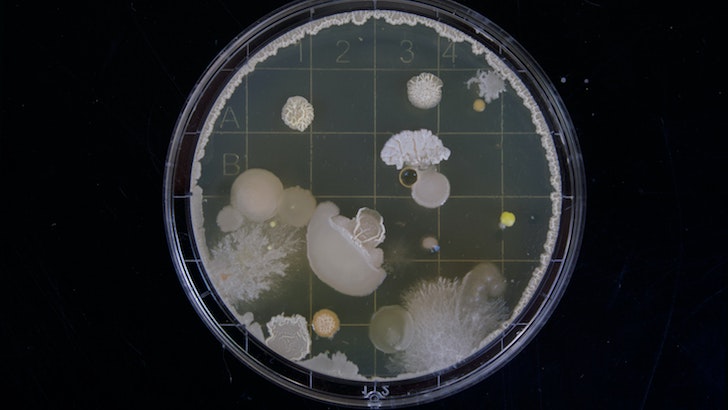

Probiyotik nedir? Probiyotiklerin faydaları nelerdir?
Bedenimizin yüzlerce çeşitteki trilyonlarca bakteriye ev sahipliği yaptığını biliyor muydunuz? Bakteri denince aklınıza yalnızca kötü bakteriler olarak bilinen patojenler gelmiş olabilir ancak vücudumuzda bulunan ‘iyi bakteriler’ hem beden hem de ruh sağlığının korunmasına yardımcı olan en önemli bileşenlerden biri. Vücutta bulunan ‘dost bakteriler’in en önemlileri bağırsaklarımızda ve sindirim sistemimizde yer alan probiyotikler. Peki probiyotiklerin faydaları neler? Bağırsak florasını doğal yollarla destekleyen, probiyotik içeren besinler hangileri? Probiyotik takviyesi alırken nelere dikkat edilmeli? Çocukların probiyotik kullanması zararlı mı? Probiyotiklerle ilgili merak ettiğiniz tüm soruların cevaplarını Uplifers olarak sizler için derledik.
Probiyotik nedir?

Probiyotik terimi, Yunanca kökenli bir kelime olup, ‘yaşam için’ anlamına geliyor. Bağırsakta yaşayan mikroorganizmaların çok önemli bir kısmını ‘dost bakteriler’, gerisini de virüsler, mantarlar ve arkealar oluşturuyor.
Sağlıklı koşullarda bu canlıların arasında hastalık yapma potansiyeline sahip az sayıda bakteri ve virüs varken, çeşitli nedenlerle bağırsak florası zarar görüp hastalık yapan mikroorganizmaların sayısı arttığında hasta olma olasılığımız da artabiliyor. Bağırsak floramızdaki dengeyi beslenme düzenindeki değişiklikler, bilinçsiz diyet yapmak, genetik faktörler, fiziksel ve psikolojik stres, bilinçsiz ve uzun süreli antibiyotik kullanımı ve doğum şeklimiz etkiliyor. Yapılan araştırmalar, bağırsakta yaşayan yararlı mikroorganizmaların dengesinin bozulmasının, yani bağırsak florasının zarar görmesinin kaygı bozukluğu, depresyon, otizm spektrumu bozuklukları, Parkinson hastalığı, Alzheimer hastalığı, migren, fibromiyalji, kronik yorgunluk, huzursuz bacak sendromu, irritabl bağırsak sendromu, sedef hastalığı ve gluten hassasiyeti gibi pek çok rahatsızlığa zemin hazırladığını gösteriyor. Sağlıklı bir yaşam tarzını benimsemiş kişilerde çok sayıda bulunabilen probiyotikler bağırsaklarda bazı besinlerin emilimini sağlamanın yanı sıra vücudun ihtiyaç duyduğu vitaminleri üretmesini de destekliyor. Sindirimin yanı sıra toksik maddelerin ve sindirilemeyen besinlerin kana geçmesini de önleyen probiyotikler, toksik maddelerin kana geçişini önledikleri için bağışıklık sisteminin de en büyük destekçisi. Son yıllarda özellikle beslenme konusunda adını sıkça duyduğumuz, ikinci beynimiz olarak anılan bağırsak florasının en önemli öğesi olan probiyotikler, aslında uzun yıllardır insan sağlığıyla ilgili hemen hemen her konuda karşımıza çıkıyor. Bağırsak sağlığı da bağışıklık sisteminin güçlenmesinde en önemli rollerden birini oynadığı için probiyotikler, her yaştan insan için sağlıklı bir vücudun temelini oluşturuyor.
Probiyotik çeşitleri
Bazı probiyotikler tek yapılı, bazıları çoklu yapılı olabiliyor. Aynı probiyotik türleri içinde bile farklı yapıda olanlar bulunabiliyor. Vücudumuzda bulunan yüzlerce probiyotik türünün sağlığımız üzerindeki etkileri de bir o kadar çeşitlilik gösterebiliyor. Bu konudaki çalışmalar henüz tamamlanmadığı için, bu etkileri tam anlamıyla bilebilmek de mümkün değil ancak şimdiye kadar yapılan araştırmalar sonucunda probiyotik olarak adlandırdığımız mikroorganizmalar genellikle Lactobacillus, Bifidobacterium ve Streptococcus grubunda bulunuyor. Bu probiyotik türleri yoğurt, kefir ve peynir gibi bazı süt ürünlerinin yanı sıra fermente besinlerin de hemen hemen hepsinde bulunabiliyor.
‘Prebiyotik’ ve ‘probiyotik’ arasındaki ilişki
Yazılışları oldukça birbirine benzeyen bu iki kelimenin kullanımı sıkça birbirine karıştırılsa da prebiyotik ve probiyotik birbirinden tamamen farklı iki kavram. Peki, prebiyotik ve probiyotik arasındaki fark ne? Probiyotikler yukarıda da detaylı olarak anlattığımız gibi bağırsaklarımızda yaşayarak bağırsak florasının doğal dengesini sağlayan, vücudumuzu zararlı mikroorganizmalara karşı koruyan, bağışıklık sistemini güçlendiren “iyi bakteriler”. Prebiyotikler ise, insanlarda sindirim enzimleri tarafından sindirilemeyen ve bazı faydalı bakterilerin çalışmasını destekleyen kısa zincirli karbonhidratlar, yani lifler. Sindirilmeyen karbonhidratlar olarak da adlandırılan lifler, yani prebiyotikler, probiyotik bakterilerin en önemli enerji ve besin kaynağı. Modern yaşama geçiş, gıda endüstrisindeki değişimler ve bilinçsiz tarım uygulamaları nedeniyle besinlerdeki probiyotik ve prebiyotik oranları da giderek azaldı. Antibiyotik kullanımının artması, çevre kirliliği, dengesiz ve sağlıksız beslenme gibi çevresel faktörler nedeniyle etkinliği azalan bu bakterilerin dengesinin korunması ve doğal yollarla vücuda alınması son derece önemli. Peki nasıl?
En iyi prebiyotik ve probiyotik kaynakları: Besinler
Bağırsaklarda yaşayan bakterilerin büyümesini, dolayısıyla da bağırsak florasındaki iyi ve kötü bakterilerin dengesinin korunmasını etkileyen en önemli faktörelerden biri beslenme düzeni. Bu nedenle de bağışıklık sisteminin %70-80’ini oluşturan bağırsak sağlığı için beslenme düzeninde mutlaka prebiyotik ve probiyotiklere ağırlık verilmesi gerekiyor.
Prebiyotik kaynakları: Lifler ve Polifenoller

Bağırsağımızda yaşayan iyi bakterilerin yani probiyotiklerin en temel besin ve enerji kaynağı yediğimiz yiyeceklerde bulunan ve mide tarafından sindirilemeyen lifler, yani prebiyotiklerdir. Dolayısıyla beslenme düzenimize yüksek lif içeren besinleri dahil etmek bağırsak floramızda yaşayan probiyotiklerin çoğalmasına ve daha iyi çalışmasına yardım eder. İki hafta boyunca prebiyotik içeriği zengin sebzeler tüketen 26 sağlıklı kişiyle yapılan bir araştırmanın sonuçları, bu kişilerin bağırsak florasında ve bağırsakta bulunan probiyotiklerin fonksiyonunda faydalı değişiklikler olduğunu gösteriyor. Lif yönünden en zengin sebze ve meyveler arasında enginar, kuşkonmaz, yer elması, pırasa, sarımsak, soğan ve muz bulunuyor.
İlginizi çekebilir: Lifli gıdalarla beslenmenin 4 önemli faydası
Bağırsak florasında bulunan probiyotiklerin sağlıklı işleyişine destek olan bir başka besin öğesi de polifenoller. Polifenol yönünden zengin olan besinlerin başında gelen meyve ve sebzeler yaban mersini gibi meyveler, çay, kahve, soğan, kuşkonm ve enginar gibi sebzeler geliyor. Ayrıca bitter çikolata da probiyotik bakterisinin besini olan liflerin kaynağı olduğu için prebiyotik yiyecekler arasında yer alıyor. Araştırmalar ayrıca kakaonun probiyotik benzeri mikrobiota içerdiğini de gösteriyor.
Doğal probiyotik kaynakları
Bağırsak sağlığının korunması için hali hazırda bağırsak florasında yer alan iyi bakterilerin prebiyotiklerle yeterli beslenebilmesi kadar bu bakterilerin doğal yollarla dışarıdan alınması da oldukça önemli. Bağırsak sağlığını düzenleyen, sindirim fonksiyonlarını destekleyen ve vücuttaki pek çok şeyin daha iyi çalışmasını sağlayan probiyotikler yönünden zengin gıdaları günlük beslenme düzeninize eklediğinizde, aslında sadece sindirim sisteminiz değil vücudunuzun tüm sistemlerinin doğru çalışmasına katkıda bulunmuş olacaksınız. Probiyotik gıda demek, yüksek miktarda yararlı bakteri içeren gıda demektir. Tüm fermente gıdalar yüksek miktarda bakteri içerirler. Yemeklerinizle dost bakteri takviyesi yapmak için, yoğurt ve kefir başta olmak üzere, fermente ev turşuları, peynirler, kombu çayı, miso ve kivas tüketebilirsiniz.

Yoğurt (Ev Yoğurdu)
En kolay erişilebilir ve en popüler prebiyotik gıdaların başında yoğurt geliyor. Hem ana öğünler hem ara öğünler için harika bir seçenek olan yoğurt, zengin bir protein kaynağı olmasının yanı sıra probiyotik yönünden de en zengin besinlerden biri. Piyasada bulunan yoğurtlar yapımları sırasında işlemden geçerken içeriğinde bulunan iyi bakterilerin de büyük çoğunluğunu kaybedebiliyor. Bu nedenle yoğurt seçerken mümkün olabildiğince organik olanları tercih etmeye, mümkünse kendi yoğurdunuzu evde yapmaya çalışın.
İlginizi çekebilir: Yoğurt deyip geçmeyin: Yoğurt ile yapabileceğiniz hem tatlı hem tuzlu lezzetler
Kefir
Fermente olmuş bir başka süt ürünü olan kefir de yoğurttan daha ince ve sulu bir yapıya sahip. İçimi oldukça kolay olan, tadı biraz süte biraz da ayrana benzeyen kefiri tek başına tüketebileceğiniz gibi smoothie’lerin içine ekleyebilir veya tahıllarla zenginleştirebilirsiniz. Laktoz oranı oldukça düşük olan kefir, laktoz hassasiyeti olanların da rahatlıkla tüketebileceği bir içecek.
İlginizi çekebilir: Kefirin faydaları nelerdir? Kefir nasıl yapılır?
Lahana turşusu
Fermente olmuş lahanadan elde edilen ve “Alman usulü lahana turşusu” diye bilinen lahana turşusu, Orta Avrupa’da yüzyıllardır tüketilen bir probiyotik kaynağı. Turşularda bulunan probiyotikler genelde fazla çeşitlilik göstermiyor olsa da, vücutta hali hazırda yaşamaya devam eden probiyotiklerin gelişimini destekleyen organik asitler, vitaminler ve sindirim enzimleri yönünden zengin oldukları için bağırsak sağlığına katkıda bulunur.
İlginizi çekebilir: Pratik turşu yapımı
Ekşi Mayalı Ekmek
Beslenme düzeninizden ekmeği çıkarmak istemiyorsanız ama bir yandan da bağırsak sağlığınız için faydalı karbonhidratlarla beslenmek istiyorsanız ekşi mayalı ekmek tüketebilirsiniz. Fermente olmuş tam buğday ve yaş maya içeren ekşi mayalı ekmek aynı zamanda diğer ekmeklere göre daha uzun süre taze kalıyor.
Kombu Çayı (Kombucha)

Bizler için kefir ve yoğurt neyse kombucha da Japonya ve Rusya’da 2000 yıldan fazladır tüketilen muhteşem bir probiyotik kaynağı. Sindirime yardımcı olması, enerji vermesi ve vücuttan toksinleri atması nedeniyle son yıllarda tüm dünyada trend haline gelmiş bu probiyotik deposu fermente çayın çok az da olsa alkol ve kafein içerdiğini unutmamak gerek. Geleneksel kombucha tariflerinde genellikle şeker bulunabiliyor. Bu yüzden içmeden önce içeriğini okumanız iyi olabilir.
İlginizi çekebilir: A’dan Z’ye kombucha: Nedir, nasıl tüketmeli, kimler kullanmalı?
Kimçi
Korelilere özgü geleneksel bir besin olan kimçi, aslında bildiğimiz sebze turşusuna benziyor. Sebzelerin laktik asit bakterileriyle fermente edilmesiyle yapılan kimçi, çin lahanası, kırmızı biber, havuç, turp, sarımsak, zencefil, deniz tuzu ve soğan gibi sebzelerin baharatla karıştırılarak yaklaşık 2 hafta kadar mayalandırılmasıyla elde ediliyor. Esmer pirinç, sebze ve et ürünleriyle birlikte tüketebileceğiniz kimçiyi salata veya yumurtayla da tüketmek mümkün.
Miso
Uzakdoğu’nun bir başka lezzeti olan miso, geleneksel Japon tıp uygulamalarında da kendine yer bulmuş, Kombucha gibi geçmişi çok eskilere uzanan, soya fasulyesinden yapılan bir çeşit macun. Miso, soya fasulyesi, arpa, esmer pirinç ve diğer bakliyatların bir çeşit küf mantarıyla fermente olmasından elde ediliyor. Farklı çeşitleri bulunan miso en çok beyaz, sarı ve kırmızı renkte satılıyor ve genelde çorbalarda tüketiliyor.
Tempeh
Soya fasulyesinin canlı küf ile fermente olmasından elde edilen tempeh, katı bir yapıya ve ekşi bir tada sahip. Genellikle parçalanarak tüketilen tempeh, her türlü yemekle birlikte protein kaynağı olarak tüketilebilir.
Natto
Japonların kahvaltıda tükettikleri geleneksel yiyeceklerinden biri olan natto, suda bırakılmış ve daha sonra buharda pişirilmiş veya doğrudan haşlanmış soya fasulyesinden yapılıyor. Daha sonra içine bacillus subtilis adı verilen bir bakteri ekleniyor ve karışım fermente olmaya bırakılıyor. Keskin kokusuna ve tadına rağmen natto önemli bir protein, lif, vitamin, mineral ve probiyotik kaynağı. Natto, ayrıca, vegan beslenmesinde eksik olan protein ve B12’yi de içeriyor.
Probiyotiklerin faydaları
Bağırsak florasının dengesinin korunması insan sağlığı açısından o kadar büyük bir öneme sahip ki, bağırsakta yer alan bakteriler son yıllarda sıkça ikinci beyin olarak da adlandırılıyor. İnsan bağırsağında 500-1000 farklı türde mikroorganizma yaşıyor. Bu mikroorganizmaların sayısı kendi vücut hücrelerimizin toplamından fazlayken, toplam ağırlıkları ise beynimizin ağırlığı kadar. Besinler aracılığıyla çeşitlendirdiğimiz probiyotikler mide ve ince bağırsaklar tarafından sindirilemeyen besinlerin sindirilmesine yardımcı olarak vücudu hastalıklardan koruyor.
Kabızlık, ishal, hazımsızlık problemlerinde, bağışıklık sisteminin güçlendirilmesinde oldukça önemlidir. Bir çalışmada araştırmacılar; probiyotik almanın, antibiyotikle kaynaklı ishali %42 azalttığını bulmuşlardır.
- Üreme yolları enfeksiyonları ve idrar yolları enfeksiyonlarının engellenmesinde etkilidirler
- B vitamini, K vitamini, folik asit ve bazı yağ asitlerinin sentezine katkı sağlarlar
- Kolesterol düzeyinin düşürülmesine yardımcı olurlar
- Kötü bakteri ve mikroorganizmalarla savaşırlar
- İrritabl bağırsak hastalıkları ile savaşırlar
- Egzama, alerji, obezite gibi birçok hastalığın önlenmesi ve tedavisinde faydalıdırlar
- Bağışıklık sisteminin güçlenmesine yardımcı olurlar
- Depresyon olasılığını azaltır veya hafifletirler
- Karaciğer güçlendirici etkileri bulunmaktadır
- Laktoz sindirimi ve antibiyotik duyarlılığında iyileşmeye aracı olurlar
- Vücut pH seviyelerinin sağlıklı sınırlarda kalmasını sağlarlar
- Hormonal dengenin korunmasına yardımcı olurlar
- Antioksidan özellikleriyle vücuttan yabancı mikroorganizmaların ve toksinlerin atılmasına yardımcı olurlar
- Yaşlanmayı geciktirirler
- Yapılan bazı araştırmalar probiyotiklerin otizm bulgularını hafiflettiğini göstermiştir
- Serotonin üretilmesine destek olurlar. Mutluluk hormonu serotoninin %90’ından fazlası bağırsaklardaki iyi bakteriler tarafından üretiliyor.
Probiyotiklere ve bağırsak florasına zarar veren alışkanlıklar
Probiyotikleri besleyen, aktivitelerini artıran, bağırsak florasının dengesinin korunmasına yardımcı olan çok sayıda besin olsa da bazı besin maddeleri ve alışkanlıklar bağırsaktaki iyi bakterilere zarar verebiliyor.
Şeker ve işlenmiş gıdalar
Şeker bağırsak geçirgenliğini artırır, hastalık yapma potansiyeli olan kötü bakterileri ve mantarları besler. Kilo almayı kolaylaştırarak bağırsak içi dengeleri daha da bozar. Ayrıca fazla miktarlarda alındığında insülin direncine neden olarak enflamasyon oluşmasına neden olabilir. Ayrıca işlenmiş gıdalar da içerdikleri şeker, katkı maddeleri ve kimyasallar ile bağırsak florasını bozar. İşlenmiş besinlerin lif içerikleri de çok düşük olduğu için dolaylı yoldan kötü bakterilerin üremesine neden olarak bağırsak sağlığını olumsuz etkileyebilir.
Antibiyotikler
Kullanılan tüm antibiyotiklerin bağırsaktaki bakterileri olumsuz olarak etkilediğine dair pek çok araştırma bulgusu var. Antibiyotik kullanımı sonrasında bakterilerin eski sayı ve çeşitliliğine dönmesi en az 1 sene alıyor ve bu geri dönüş de ne yazık ki %75-90’larda kalıyor. Tabii ki doktorunuzun önerisi ile kullandığınız antibiyotikler sağlığınızı korumanız açısından hayati öneme sahip. Ancak doktorunuz önermediği halde nezle, öksürük, soğuk algınlığı gibi durumlarda kendi insiyatifinizle antibiyotik kullanmanız uzun vadede çok daha ciddi sağlık problemleriyle karşılaşmanıza sebep olabilir.
Alkol
Alkolün kendisinin bir şeker olduğunu biliyoruz. Ayrıca pek çok alkollü içeceğin içerisinde yüksek miktarlarda ilave şeker bulunuyor. Alkol ayrıca bağırsak bağlantılarını etkileyerek artmış geçirgenliğe de neden oluyor. Yani alkol aldığınızda bağırsağınızdaki yararlı mikroorganizmaların işlevsiz hale gelmesine neden olmanın yanı sıra bir de zararlı maddelerin kanınıza karışmasına izin vermiş oluyorsunuz. Bu yüzden alkol tüketiminize dikkat etmeniz bağırsak sağlığınızı korumanız açısından büyük bir öneme sahip.
Çocukların probiyotik kullanması zararlı mı?
Probiyotikler, bebeğin normal doğum ile doğum kanalından geçmesinden itibaren vücuda yerleşir, anne sütü ve ilerleyen zamanlarda alınan takviye gıdalarla da sayıları giderek artar. Yeni doğanların çoğunun kabızlık problemi yaşamasının sebebi bağırsak florasının yeterince gelişmemesidir. Özellikle sezaryen ile doğan ve yeterince anne sütü ile beslenemeyen bebekler bu sorunu sık sık yaşayabilirler. Probiyotik takviyeleri, vücuda besinler yoluyla probiyotik alınması ve alınan probiyotiklerin prebiyotiklerle desteklenmesi hem yetişkinler hem de çocuklar için son derece önemli. Probiyotik kullanan ve kullanmayan okul çağındaki çocuklarla yapılan bir araştırma sonuçlarına göre, anaokulu çağındaki çocuklara probiyotik verildiğinde hem hasta olma oranları düşüyor hem de hasta oldukları zamanki tedavi süreçleri kısalıyor. Ancak her çocuğun gelişiminin farklı olduğunu, her yaşın kendine özgü beslenme gerekliliklerinin bulunduğunu ve bu nedenle probiyotik alımında da çocuğun sağlık durumunu, ihtiyaçlarını ve gelişim özelliklerini gözetmeniz gerektiğini unutmamalısınız.
Probiyotik takviyeleri

Eğer fermente gıdalarla aranız pek iyi değilse ve sevmediğiniz için yeteri kadar tüketemiyorsanız, ya da aldığınız miktar ve çeşidi artırmak istiyorsanız, eczaneden probiyotik takviyesi alabilirsiniz. Aldığınız ürün en az 5-10 milyar cfu (kob, koloni oluşturan bakteri) bakteri içermeli, mide asidinden daha az etkilenmesi için kapsül içerisinde olmalı ve en az 5 çeşit değişik bakteri türü içermelidir. Hem çocuklar hem de yetişkinlerin kullanması gereken probiyotikler sağlık için son derece önemli olsa da probiyotik takviyesi seçiminde ve bu takviyeleri kullanmadan önce dikkat etmeniz gereken oldukça önemli noktalar var. İyi bir probiyotiğin özelliklerini şöyle sıralayabiliriz:
- Patojen olmamalı
- Toksinojen olmamalı
- Depolama ve kullanım sırasında canlılığı korumalı
- Bağırsakta canlı kalmalı
- Sağlık üzerine olumlu etkiler oluşturmalı
Kaynaklar:
Journal of Gastroenterology and Hepatology
Harvard Helath Publishing
Medical News Today
BBC Good Foods